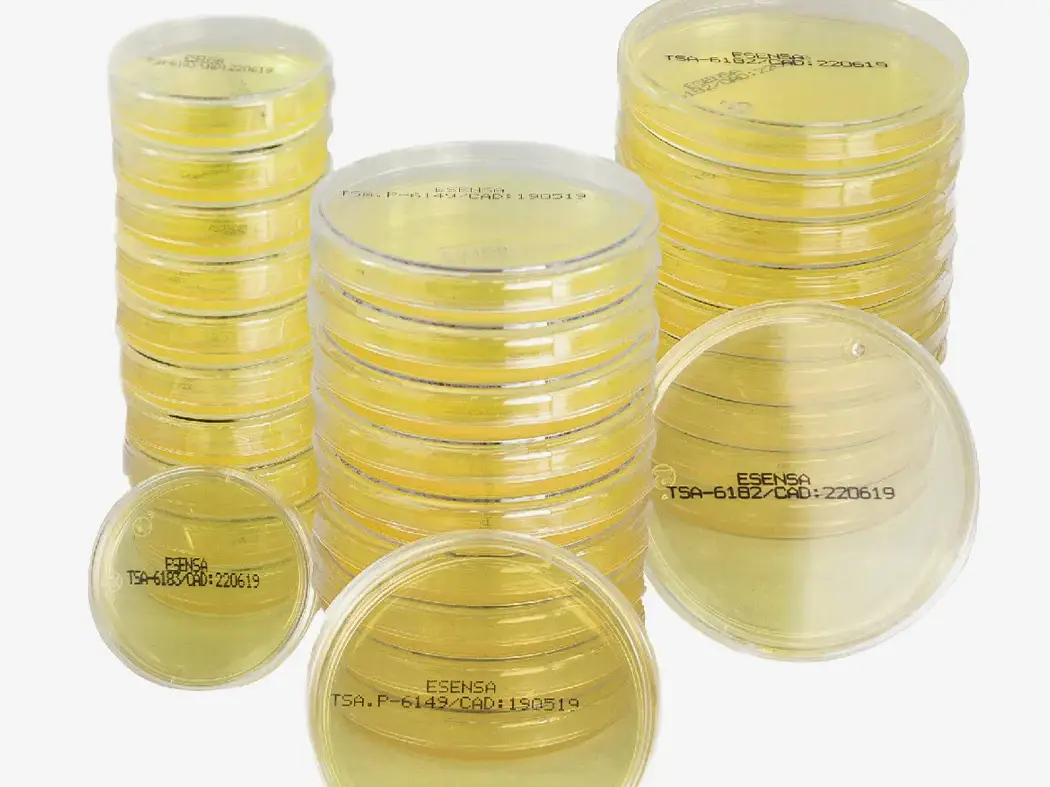

We collaborate with best designers & talents to create an evolving collection
With the Uncode Home Planner you can plan and design your kitchen, bathroom or your office.
Our home furnishing consultants can help you with advice on your refurnishing or decorating project.
Need help putting the furniture together? Assembly service is available with any purchase.
Purchase everything, we charge the same delivery fee regardless of the weight of the order!
Showroom
9876 Design Blvd,
Suite 543, Beverly Hills,
CA 90212